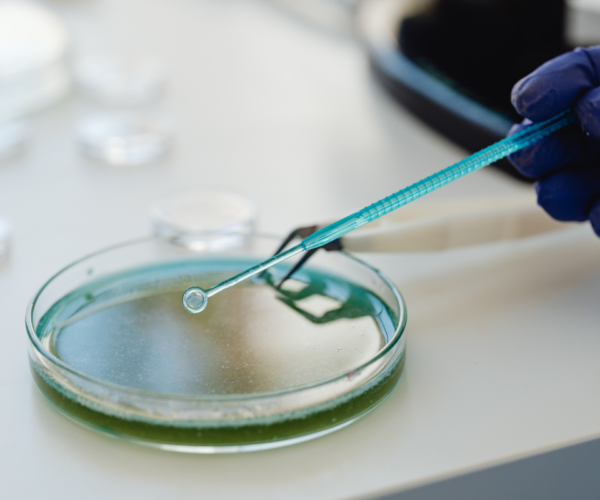
Untitled design (34)

High Performance Laboratory Services
Our Premium Services
Our mission is to provide the highest standard of clinical laboratory service to physicians, clinics, hospitals, and health care providers.
Advanced softeners, silicone emulsions, wrinkle-resistant agents, and fabric enhancers designed to improve texture, durability,…
Read More
High-grade tanning agents, fatliquors, dyeing chemicals, and finishing auxiliaries for superior leather strength, flexibility,…
Read More
Premium reactive, disperse, and specialty dyes formulated to deliver vibrant shades, excellent fastness, and…
Read More